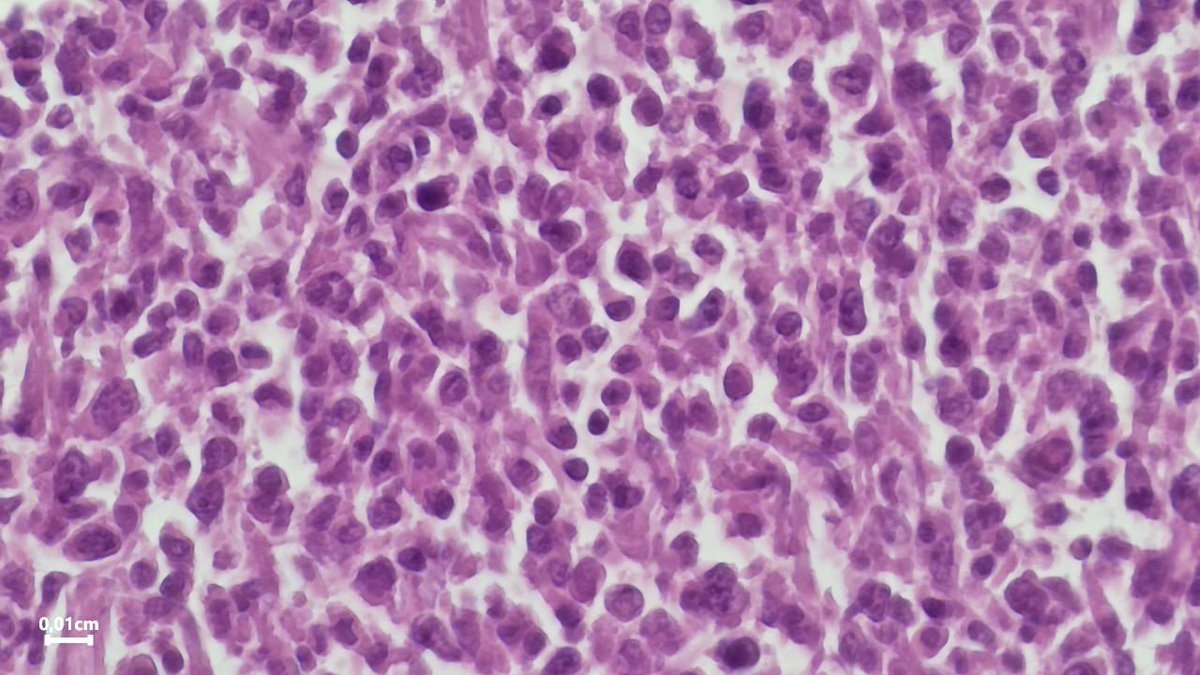
Drmerm's tweet image. A 59-year-old female. spleen mass
#PathTwitter #pathology  #medpath #MedTwitter #xpath #pathtweetaward #GIpath #pathology #PathTwitter #hemepath

#medpath Suchergebnisse
Medical school always humbles you, if it doesn't, it's a failed mission. #medpath
Meckel’s Diverticulum Embryology: Arises from Incomplete Closure of Omphalomesenteric Duct. Clinically: Frequent cause of GI bleeding in children < 2 years Pathology: Can have ectopic tissue like stomach and pancreas #pathagonia #pedspath #medpath #medicalstudent #gi #surg


🐟🌊 ¿Conoces los logros alcanzados por #MedPath en la mejora de la #Sostenibilidad de las pesquerías del Mediterráneo? Descubre todos los detalles en el "Informe de Impactos de MedPath". 📰 🔗 bit.ly/49qwEl7 #MedFish #BluFish #HellasFish #SelloAzul #PescaSostenible

4/ Miquel Ortega, investigador posdoctoral del @ICMCSIC y miembro del equipo científico del Proyecto SEINE-ETP. Sus principales áreas de interés son la economía ecológica marina y la ecología política. #MedPath #SeineETP #UNOD #Pescasostenible

🎣 🎣 #MedPath ¿Sabías que el Proyecto #Medfish mapeó 100 pesquerías en España y Francia? Descubre cómo se está impulsando la #Sostenibilidad en el #Mediterraneo 📰🔗 bit.ly/3TJzcVI #BluFish #HellasFish #SelloAzul #PescaSostenible #MaresParaSiempre

Domani a Malta all’evento "Discovering Pathways to Sustainable Mediterranean Fisheries" nell'ambito della Conferenza GFCM su ##MedFish4Ever parleremo del ruolo di #Medfish e #MedPath nella transizione verso la #sostenibilità della pesca nel Mar #Mediterraneo.

Domani saremo a Barcellona alla conferenza "Decennio degli Oceani" delle Nazioni Unite per parlare del Mar Mediterraneo con WWF Spagna e l'Istituto di Ricerca Marina di Barcellona. Sei ancora in tempo a partecipare, registrati qui: bit.ly/3Te7y2V #unoceandecade #MedPath
Team @MSCenEspana and @MSCinItalia ready for @UNOceanDecade side event on #Medpath #Mediterraneo #BCN

Q:Caseous necrosis is classically seen in ? A. Syphilis B. Tuberculosis C. Leprosy D. Sarcoidosis #Necrosis #pathology #Medpath

🎙️¡En el programa de @ecogestiona de hoy se va a hablar sobre el informe #MedPath! @julioagujetas__ , Senior Fisheries Manager en @MSCenEspana, analizará los puntos más destacados y compartirá sus impresiones sobre el lanzamiento oficial del informe en la @UNOceanDecade ⤵️⤵️
En la segunda parte hablaremos del informe MedPath de @MSCenEspana sobre la pesca en el Mediterráneo. Conoce los desafíos y soluciones hacia una #pescasostenible de la mano de Julio Agujetas, coordinador del informe. #OceanDecade24

Excellent collaboration between @IIM_CSIC and #Medpath in Spain. Examples of research and learnings with Palamos red shrimp fishery and Castellon sardine and anchovy. Mutual learning for better understanding of ecosystem and fishing impact. @UNOceanDecade

3/ @julioagujetas__ responsable de pesquerías del Mediterráneo de @MSCenEspana, con más de 20 años de experiencia en investigación y evaluación de impactos en ecosistemas marinos, y coordinador del proyecto #MedPath. #PescaSostenible #MedFish #SelloAzul

📣 Join us in Malta for the "Discovering Pathways to Sustainable Mediterranean Fisheries" side event during the GFCM's #MedFish4Ever Conference! 🌊🐟 Discover #Medfish #MedPath's role in Mediterranean fisheries' #Sustainability transition! @julioagujetas__ @OPPMOTRIL @UN_FAO_GFCM

💡 Expertos del @ICMCSIC, @WWFespana y @MSCenEspana debaten sobre los avances del #Mediterraneo en el marco de la @UNOceanDecade durante el evento satélite Restoring European seas. ¡Todos los detalles en nuestra noticia! #PescaSostenible #MedPath #UNOD bit.ly/3UaHnMc
👍🎣 ¡Las pesquerías involucradas en el programa #MSC siguen generando un gran impacto, con 417 mejoras en los últimos 3 años! En el Proyecto #MedPath, han participado 34 pesquerías, 7 instituciones científicas, gobiernos locales y ONG. 🔗 #InformeAnual: bit.ly/3U6tEFG

His hard work, perseverance, and passion for science truly paid off. We can’t wait to see where his talents take him next. Join us in celebrating this outstanding achievement! #Prep #MedPath #PJAS 🔬
The curiosity was in full swing. Students asked thoughtful questions and many are already planning to shadow in the coming weeks to learn even more. A huge thank you to AHN for investing in our students and helping bring healthcare careers to life! #Prep #MedPath ⚕️

To top it all off, Guardians star José Ramírez made a surprise guest appearance! Yesterday was an incredible behind-the-scenes experience filled with learning, inspiration, and unforgettable moments! #Prep #MedPath ⚕️⚾




Q:Caseous necrosis is classically seen in ? A. Syphilis B. Tuberculosis C. Leprosy D. Sarcoidosis #Necrosis #pathology #Medpath

Gio reminded the students why they are choosing to pursue careers in medicine, to bring hope and healing to others. Everyone left UPMC feeling inspired, grateful, and more motivated than ever to make a difference! #Prep #MedPath #GioStrong ⚕️🏥



· Choose a career with a work-life balance that fits you. · And most of all, find the beautiful moments during your educational journey. Thank you, Mary, for inspiring our students to dream big, work hard, and think smart! #MedPath #PhysicalTherapy

🌟 Excited to support the Ohio State MedPath program and empower future healthcare leaders! Together, we can make a difference in our communities. Let's cultivate growth and opportunity! 💙 #MedPath #GivingBack #FutureDoctors #HealthcareHeroes #OSU #Philanthropy


later adding certifications in performance enhancement and strength & conditioning coaching. His story showed students that there’s more than one path to a career in health sciences. Our students were highly engaged, asking great questions throughout his talk. #Prep #MedPath ⚕️
Can you extend the list of similar findings in other lesions, as seen in the marked ones in the picture below? 🤔 I’ll go first 1. LCH #medpath #pathsurg #histopath #pathx #pathtwitter #Medicine

Participants were able to gain insight into current topics, trends, and innovations in the nursing field and imagine their own future in healthcare while networking with professionals. #MedPath #FutureHealthcareLeaders 🩺

Meckel’s Diverticulum Embryology: Arises from Incomplete Closure of Omphalomesenteric Duct. Clinically: Frequent cause of GI bleeding in children < 2 years Pathology: Can have ectopic tissue like stomach and pancreas #pathagonia #pedspath #medpath #medicalstudent #gi #surg


4/ Miquel Ortega, investigador posdoctoral del @ICMCSIC y miembro del equipo científico del Proyecto SEINE-ETP. Sus principales áreas de interés son la economía ecológica marina y la ecología política. #MedPath #SeineETP #UNOD #Pescasostenible

🐟🌊 ¿Conoces los logros alcanzados por #MedPath en la mejora de la #Sostenibilidad de las pesquerías del Mediterráneo? Descubre todos los detalles en el "Informe de Impactos de MedPath". 📰 🔗 bit.ly/49qwEl7 #MedFish #BluFish #HellasFish #SelloAzul #PescaSostenible

Keratoacanthoma with malignant transformation may be cutaneous squamous cell carcinoma with KA-like features and might be detected more readily by routine use of p16 and p53. Read more in our 'Controversies in Pathology' series. rcpa.me/Keratoacanthoma #Pathology #MedPath

Team @MSCenEspana and @MSCinItalia ready for @UNOceanDecade side event on #Medpath #Mediterraneo #BCN

Q:Caseous necrosis is classically seen in ? A. Syphilis B. Tuberculosis C. Leprosy D. Sarcoidosis #Necrosis #pathology #Medpath

🎣 🎣 #MedPath ¿Sabías que el Proyecto #Medfish mapeó 100 pesquerías en España y Francia? Descubre cómo se está impulsando la #Sostenibilidad en el #Mediterraneo 📰🔗 bit.ly/3TJzcVI #BluFish #HellasFish #SelloAzul #PescaSostenible #MaresParaSiempre

Domani a Malta all’evento "Discovering Pathways to Sustainable Mediterranean Fisheries" nell'ambito della Conferenza GFCM su ##MedFish4Ever parleremo del ruolo di #Medfish e #MedPath nella transizione verso la #sostenibilità della pesca nel Mar #Mediterraneo.

Excellent collaboration between @IIM_CSIC and #Medpath in Spain. Examples of research and learnings with Palamos red shrimp fishery and Castellon sardine and anchovy. Mutual learning for better understanding of ecosystem and fishing impact. @UNOceanDecade

A 71-year-old man presenting with frontal syndrome and headaches. Frontal meningioma. What do you think? #PathTwitter #pathology #medpath #MedTwitter #xpath #pathtweetaward #neuropath #meningioma #BrainTumor #PathBoards #patologia #neurooncology #pathart #brain #neurosurgery




👍🎣 ¡Las pesquerías involucradas en el programa #MSC siguen generando un gran impacto, con 417 mejoras en los últimos 3 años! En el Proyecto #MedPath, han participado 34 pesquerías, 7 instituciones científicas, gobiernos locales y ONG. 🔗 #InformeAnual: bit.ly/3U6tEFG

A 59-year-old female. spleen mass #PathTwitter #pathology #medpath #MedTwitter #xpath #pathtweetaward #GIpath #pathology #PathTwitter #hemepath

📣 Applications are open for our Postdoctoral Training Program in Clinical Microbiology! As a future Clinical Microbiologist, we prepare you to become competent in all aspects of this fascinating field. Applications are due September 20. lmp.utoronto.ca/clinical-micro… #medpath #uoft

7/ En el taller sobre #MedPath, se destacó cómo varias iniciativas han generado un impacto positivo tanto en la recopilación de datos como en la gestión de las pesquerías en el #Mediterraneo. Más información ➡️ bit.ly/3TJzcVI #PescaSostenible #UNOD


3/ @julioagujetas__ responsable de pesquerías del Mediterráneo de @MSCenEspana, con más de 20 años de experiencia en investigación y evaluación de impactos en ecosistemas marinos, y coordinador del proyecto #MedPath. #PescaSostenible #MedFish #SelloAzul

🌊🎣 ¡Explora el fascinante panorama de la #PescaSostenible! Durante la última década, se ha logrado reducir significativamente la presión sobre las poblaciones marinas en el #Mediterraneo. Todos los detalles en el artículo de @eroskiconsumer 🆕 bit.ly/43CFVVL #MedPath

Something went wrong.
Something went wrong.
United States Trends
- 1. #Survivor50 N/A
- 2. Stone Age N/A
- 3. NASA N/A
- 4. Simon's Cat N/A
- 5. Artemis II N/A
- 6. #PresidentialAddress N/A
- 7. #AEWDynamite N/A
- 8. Sharks N/A
- 9. Macklin Celebrini N/A
- 10. #TheFutureIsTeal N/A
- 11. #ONEPIECE1179 N/A
- 12. Gavin Williams N/A
- 13. Colby N/A
- 14. Genevieve N/A
- 15. Challenger N/A
- 16. Blackwood N/A
- 17. Super Mario Galaxy N/A
- 18. SpaceX N/A
- 19. Monkey Kings N/A
- 20. Kamilla N/A











































